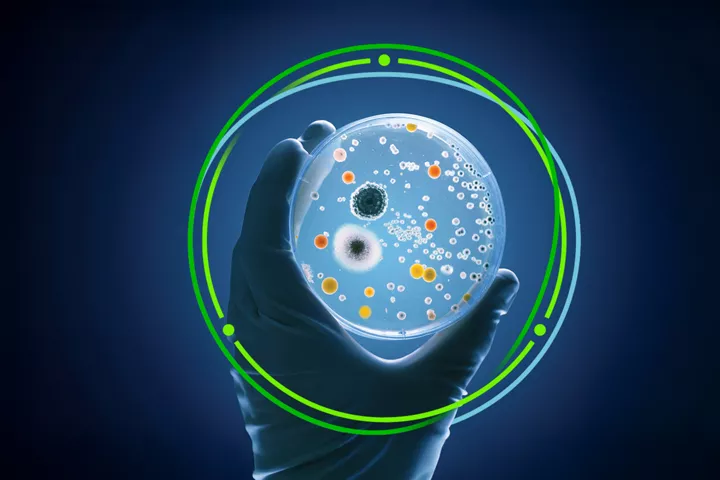

Link opens in a new tab
opens in new window
Audit and assurance services tailored to your industry
Innovation that empowers progress
Thriving amid disruption
Companies across industries face a myriad of business disrupters, including evolving regulations, complex economic conditions, and rapid technological advancements. To help navigate these challenges, Deloitte & Touche LLP integrates audit and assurance services with technology-enabled capabilities and seasoned industry perspective.